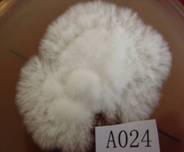

生物工程系特长生课题介绍
1、课题题目:猴头菇的菌种驯化与栽培技术优化
2、研究内容:猴头菇是一种药食两用真菌。实用价值是:它是鲜美无比的山珍,菌肉鲜嫩,香醇可口,有“素中荤”之称,长期以来,人们把它同熊掌、海参、鱼翅共同列为“四大名菜”,或把它与燕窝相提并论。药用价值主要有:1、抗溃疡和抗炎作用; 2、抗肿瘤作用;3、保肝护肝作用;4、抗衰老作用;5、提高机体耐缺氧能力,增加心脏血液输出量,加速机体血液循环;6、降低血糖和血脂的作用。
优质的猴头菇色泽洁白、子实体圆而厚、布满针状菌刺,形状极似猴子的头,食之肉质鲜嫩,味香可口。
猴头菇人工裁培在各地已形成不同程度规模。突出的问题是产量虽能达标,但高品位产品的比率不多,降低了商品价值,影响生产者经济效益。
本课题拟从两个方面来改善猴头菌的性状:一是从菌种的优化做起,猴头菌比较容易出现的缺陷是子实体不够圆而厚,和色泽不够洁白,优选国内较知名的猴头菌种,并对其进行驯化,使性状更加适合经济化生产;二是从猴头菇的栽培做起,通过对培养基成分的筛选,选育出更加适合猴头菇生产的优质培养基搭配。
3、本课题对本专业教学及学生能力培养所起的作用:
食用菌是微生物的一个重要分支,且是肉眼可见的大型微生物。
通过本课题的研究,可使我从实践中了解微生物生长的条件、微生物培养基的配制和优良培养基的筛选以及食用菌工业化生产的步骤。而且可使我在本专业今后的教学中能够更多的理论联系实际,为今后的教学提供更多的实践素材。
通过对猴头菇的菌种驯化、栽培试验以及对其生长特性的观察,可使学生更好地掌握微生物的培养、菌种选育的相关工作,并初步了解食用菌工业化生产的相关信息。通过本课题的参与,不仅可以牢固的巩固所学的微生物学知识,还可以可锻炼学生的动手能力以及科学的思维模式。为他们今后的工作和生活提供很好的锻炼机会。
4、特长生参与课题工作的培养目标和培养计划:
特长生通过参与本课题,达到以下的培养目标:
1、能够独立进行培养基的配置和利用正交法进行培养基的筛选工作
2、能够熟练进行菌种的培养和栽培的工作
3、具备独立进行文献检索的能力
4、能够科学的进行实验设计、实验结果整理和实验结果的分析工作
特长生培养计划:
独立查阅文献,在导师的指导下进行实验设计,进行科学的试验操作,真实地记录实验结果,分析实验结果,并进行实验总结。
5、特长生参与课题研究工作后具备的技能和将达到的水平:
1、具备独立的查阅文献的能力;
2、初步掌握科学地进行实验设计的方法;
3、具备严谨科学的工作态度和诚信的人生信条;
4、掌握猴头菇的菌种驯化和大规模栽培技术。
6、特长生名单:史艳辉、葛友军、黄静、魏书晓、战巧娜、陈晨、梁小丰、裴金花、武雪荣、苏丙顺、刘阳、李胜
7、试验图片
接种


母种的生长状况

平板培养结果
8、实验结果
通过我们的实验,获得了一株优良的品种,并获得了关于栽培的相关条件的最优组合。
9、特长生的收获
l 首先在查阅资料上,刚开始无从下手,经过了三次会议,每次老师都进行有针对性的指导,使我们利用网络和图书馆的资料查阅到了自己所需的知识。
l 其次在实验设计上,初始的设计往往浮于表面,设计的实验不具备可操作性,经过与老师进行的数次深入讨论与更改实验方案,最终确定了实验方案。
l 第三在实验操作中,我们虽然已经掌握了基本实验技能,但是熟练程度不够,有时还会有一些手法上的不够准确,所以重复性较差,经过一个学期的试验锻炼,现在已经达到了熟练操作的程度。
l 第四,在实验结果的分析上,有些结果与预想的一致,我们能够对结果进行分析和解释,但是,当结果不一致时,就难以找到合理的解释。这说明我们对此部分的基本知识和基础理论还有欠缺,以后若从事此方面的工作,还有待加强。
l 经过这次特长生课题的锻炼,使我们不仅从基本知识、基础理论上有了加强,而且大大锻炼了他们的动手能力,而且还掌握了查阅资料的能力以及分析问题、解决问题的能力。